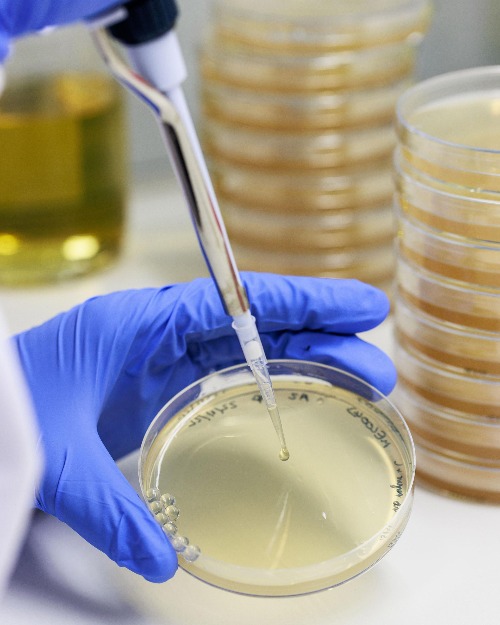
10 AI Applications Shaping the Future Picture 2

10 AI Applications Shaping the Future
From medical innovations to conservation and sustainability, TIME takes a look at how new AI innovations are making an impact.
Artificial intelligence (AI) is pushing new frontiers in science and technology — from controlling military drones, diagnosing diseases, to designing enzymes that can break down plastic waste.
Meanwhile, user-facing AI chatbots are already used by hundreds of millions of people every week, creating profound changes in education, child development, and human connection. TIME magazine looks at 10 ways AI innovation is shaping the future.
Vaccine development
The rapid development of a COVID-19 vaccine has many factors: years of mRNA research , strong political will, and massive funding. But to shorten the timeline from 15 years to just 12 months, scientists have relied on a new arsenal of AI tools, from genome sequencing to clinical trial data processing.
Similar tools are also helping to speed up vaccine development. Given a pathogen with pandemic potential, ' we can design a new vaccine in just a few days ,' says Timothy Endy , program leader at the Coalition for Epidemic Preparedness Innovations (CEPI) — a public-private partnership that promotes vaccine development. CEPI's goal is to develop and deploy a new vaccine within 100 days . ' I think we're almost there ,' Endy says.
Human-machine relationship
Human-machine relationships are becoming commonplace. Millions of people are turning to AI chatbots to fill a role that blends friend, therapist, and romantic partner. One AI role-playing platform, Character.AI, now has 20 million monthly active users—half female, half born after 1997.
' For many people, this is a valuable form of entertainment ,' says Kate Devlin, a professor at King's College London who studies AI and human-computer intimacy. She argues that companion AI can be beneficial, as long as people understand that AI is not conscious. However, she also warns that vulnerable people—especially children or people with mental health problems—could be exploited by sharing their innermost feelings with AI tools that are not designed for therapy. Still, with usage on the rise, Devlin believes society is flexible enough to adapt to this transition. ' We're very good at being human, ' she says.
Wildlife monitoring
To monitor wildlife, conservationists use networks of motion-sensor cameras in some of the world's most remote areas. But the vast amount of footage collected can take weeks to sift through before a single moment of interest is found.
The Wildlife Insights tool , developed through a collaboration between the World Wildlife Fund (WWF), Google, and partners, uses AI to scan millions of images with 99.4% accuracy, helping researchers focus on more important work, according to Abby Hehmeyer, program leader at WWF.
In March, the tool was open-sourced, after being trained on 65 million images, so that any conservationist could use it. ' The threats to biodiversity are overwhelming ,' Hehmeyer said. ' This tool allows us to react quickly to the speed at which threats are coming .'

Education
While educational institutions are scrambling to control AI, the technology's adoption is growing. In July, US teachers' unions partnered with OpenAI , Microsoft , and Anthropic in an initiative to train 400,000 teachers to use AI over the next five years. In August, OpenAI announced a partnership with the Indian government to deploy AI in schools nationwide.
According to Rose Luckin , a professor at University College London with extensive experience in AI in education, the widespread use of AI by students has disrupted systems that were already ill-prepared for the future. However, she argues that these changes also open up new opportunities, although regulation and a clear understanding of the limits of AI are necessary to protect vulnerable groups.
She said: ' The core thing we need to understand is: what kind of relationship do we want to build between human intelligence and artificial intelligence? '
Circular recycling
More than 350 million tons of plastic waste are generated every year. But AI-designed enzymes could ' un-bake the cake— turning plastic back into the original chemical compounds it was made from—opening up infinite recycling possibilities for all the materials that are currently landfilled or burned, ' says Jacob Nathan, founder and CEO of London-based Epoch Biodesign.
The company has engineered enzymes for three major groups of plastics using machine learning , breaking down not only textiles but also packaging and a variety of other materials. The startup, which began as Nathan's high school project in 2019 and has raised $35 million, will complete its first industrial-scale manufacturing plant later this year, with an expected capacity to process 150 tons of waste per year , Nathan said.
Medical diagnosis
AI tools that help diagnose strokes, cancer, and many other medical conditions are becoming a fixture in healthcare systems around the world. Qure.ai , which uses AI to analyze diagnostic images like X-rays and ultrasounds, is now deployed in more than 4,500 locations in more than 100 countries . Viz.ai 's diagnostic algorithms are also being used in more than 1,800 hospitals across the United States and Europe.
The AI system has also shown potential as a clinical assistant. In a pilot study conducted by Kenyan primary care provider Penda Health in collaboration with OpenAI, Penda's AI system — designed to supplement clinicians' knowledge and already applied to thousands of patients — reduced medical diagnostic errors by 16%.
With the rate of adoption increasing, global healthcare is poised for dramatic improvement.
Children's toys
AI toys are a nascent but growing market. Companies like Curio sell AI-powered stuffed animals that can converse with young children in age-appropriate language, one designed and voiced by musician Grimes . Others, like Miko 3—an ' interactive robot that teaches and listens '—are designed to aid learning. In June, OpenAI partnered with toy maker Mattel; the first product is expected to be announced later this year.
However, without safeguards, these toys could impact key developmental stages in childhood, warned Anne-Sophie Seret, chief executive of everyone.AI — a global initiative working with governments and businesses to keep children safe when using AI.
She says that standards, guidelines and proactive involvement of toy design companies are essential. ' Once a teddy bear is under the Christmas tree ,' she says, ' it's hard to get it back. '
Mapping the Earth
In July, Google announced an AI system that acts as a 'virtual satellite,' fusing optical, thermal, radar, climate and other data to accurately depict Earth's land and coastal regions.
The resulting merged dataset ' gives scientists and researchers a globally consistent understanding of the planet ,' explains Christopher Brown, senior research engineer at Google DeepMind.
The computationally efficient, customizable maps enabled by this model—already in use by more than 50 organizations—can serve governments, companies, nonprofits, and academics for a wide range of tasks, from mapping ecosystems and supply chains to analyzing how the planet changes over time. Brown is optimistic that, by removing barriers to entry, the technology could lead to 'an explosion in Earth science.'
Factory automation
While industrial robots have been around on factory floors since the 1930s, their brains have only recently begun to catch up to their mechanical prowess. Xiaomi now operates a dark factory in Beijing—so automated it can run with low lighting—that produces a flagship smartphone every six seconds with just a few technicians overseeing the system.
Meanwhile, German technology giant Siemens is pioneering AI-powered industrial assistants that help engineers control robots using natural language and automatically identify mechanical problems, resulting in up to a 30% increase in efficiency, according to Peter Koerte, chief technology and strategy officer. He added that much of AI's future impact depends on transforming the industrial world. " After all, that's a large part of the economy ."
Self-driving drones
Autonomous drones are becoming one of the most important advances in AI and robotics technology. Instead of relying entirely on remote control, these devices are equipped with smart sensors and algorithms, allowing them to navigate, recognize objects, avoid obstacles and adjust their routes in real time.
Applications for autonomous drones range from environmental monitoring, precision agriculture, cargo delivery, to emergency rescue assistance in rugged areas. Some models are also capable of coordinating in a 'swarm' form, extending the range of operations and increasing efficiency when deployed over large areas, such as forest monitoring or searching for missing people.
With their flexibility and ability to minimize direct human intervention, autonomous drones promise to become a powerful tool to optimize production, protect the environment and improve quality in many fields.
- Advanced user interface for applications with animations
- Using eBox like Gateway: Firewall, Traffic Shaping, HTTP Proxy ...
- The 10 major new technologies that were recently killed have made many people regret it
- Marvel Future Revolution - Download Marvel Future Revolution
- 16 applications that help students learn more effectively
- Status, good quotes about the future, orienting the road ahead
- 7 evidence that the Netherlands is a country of the future
- Blind prophet Vanga and the predictions of disaster came in 3797






 Scientific breakthroughs in 2025 that could change everything
Scientific breakthroughs in 2025 that could change everything Human blood successfully created in lab opens new era for regenerative medicine
Human blood successfully created in lab opens new era for regenerative medicine Dogs have the ability to think like humans, even smarter than children.
Dogs have the ability to think like humans, even smarter than children. How to Identify Visitors in No, I'm Not a Human
How to Identify Visitors in No, I'm Not a Human What would humanity be like if they lived in a level 7 civilization?
What would humanity be like if they lived in a level 7 civilization? New AI can 'read human behavior' with unprecedented accuracy
New AI can 'read human behavior' with unprecedented accuracy